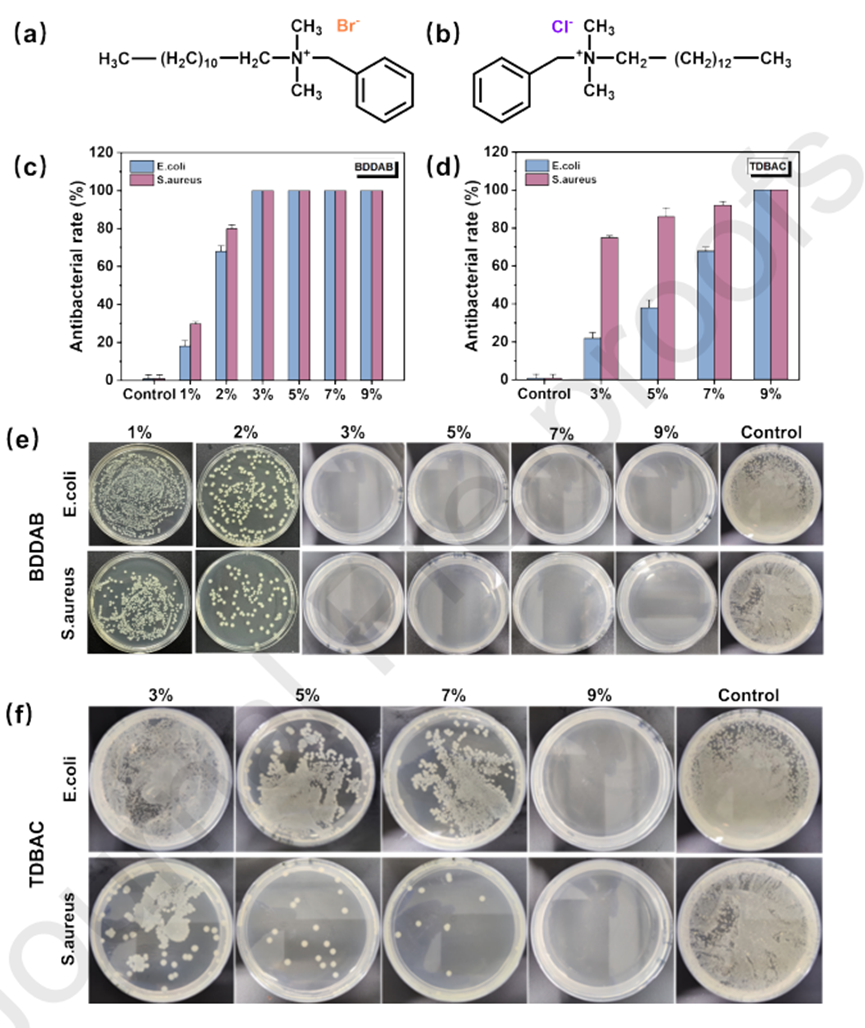

近日,苏州大学张克勤教授团队和南方科技大学王湘麟讲席教授、陈柔羲副教授团队在期刊《Chemical Engineering Journal》上,发表了最新研究成果“Biodegradable Micro-Nanofiber Medical Tape with Antibacterial and Unidirectional Moisture Permeability”。研究者通过合成可生物降解的扩链改性的聚碳酸亚丙酯与静电纺丝工艺相结合,制备得到负载抗菌成分的PPC纳米纤维膜材料。通过对改性PPC弹性体及抗菌成分的筛选,以HMDI-BDO改性PPC为原料,以苯扎溴铵作为抗菌剂,通过与工业级疏水聚氨酯纳米纤维膜相复合,制备得到具有单向导湿性能的抗菌微纳米医用胶带AMMT-3。这种胶带(AMMT-3)具有优异的透气性(43.07 mm·s,是3M、同类商品的2.3倍)、透湿性(6,589.40 g/(m2·d))和亲肤性。此外,该胶带具有出色的抗菌性能,具有100%的抗菌率,加上其生物降解性,使其成为医用敷料和组织工程应用中非常有前途的材料。

图1:改性PPCs弹性体的合成工艺。
碳酸丙烯酯(PPC)是一种环境友好且可生物降解的聚合,由二氧化碳(CO2)和环氧丙烷(PO)合成。它具有理想的生物降解性、良好的生物相容性、优异的氧气阻隔性能、和足够的室温韧性。这些特性使其成为应用于包装、粘合剂和生物医学材料的潜力材料。然而,PPC中大量醚键的存在导致极低的玻璃化转变温度(Tg)和差的机械强度。在高于40°C的温度下,它还表现出较差的尺寸稳定性。因此,为了改善PPC的机械性能和功能特性,需要对PPC进行进一步的扩链改性处理。如图一所示,通过选取五类不同的异氰酸酯和五类不同的二元醇做扩链剂,合成的得到九种改性的PPC 弹性体。对不同的PPC弹性体进行分子量,溶解性及FTIR、力学强度等性能表征(图2),HMDI-BDO被认为是最适合进行后续加工的PPC弹性体。

图2:改性PPCs弹性体的性能表征。
静电纺丝工艺是一种可以有效将高分子材料与抗菌剂偶联的膜材制备工艺。本项研究选取天然类、有机类及无机类的抗菌剂代表,对比得到不同类别的抗菌剂掺杂的HMDI-BDO微纳米纤维膜的抗菌效果。如图3所示,季铵盐类表现出最为优异的抗菌效果。

图3 不同抗菌剂的抗菌效果。
如图4所示,进一步评估和比较季铵盐类抗菌剂苯扎溴铵(BDDAB)和十二烷基二甲基苄基氯化铵(TDBAC)。发现含有BDDAB的HMDI-BDO AMFMs在含量高于3%时表现出100%抑菌率的最佳抗菌性能。BDDAB表现出优异的有效性,对金黄色葡萄球菌的最大抑制环尺寸为17.8±3.0 mm,对大肠杆菌的最大抑制环尺寸为12.2±2.0 mm。这是因为溴离子具有较强的反应性,在水中产生的溴自由基具有较强的氧化能力。
图4 季铵盐类抗菌剂抗菌效果比较。
AMMT-3是将浓度为3%BDDAB的HMDI-BDO MFM与工业级疏水性TPU纳米纤维膜相结合开发的单向、透湿、抗菌微纳医用胶带。AMMT-3表现出优异的透气性,是目前3M商用AMT的1.2倍。此外,当应用于皮肤表面时,它不会引起任何过敏或炎症反应。AMMT-3表现出的卓越性能使其在医用敷料和组织工程领域的各种应用中具有很高的前景(图5)。

图5 微纳米抗菌可降解医用胶带材料性能。
论文链接:
https://doi.org/10.1016/j.cej.2023.145793
人物简介:
张克勤教授:苏州大学纺织与服装工程学院院长,苏州市第十五届政协委员,苏州大学现代丝绸国家工程实验室特聘教授,博士生导师。在Nature, Nature Communications, Physical Review Letters, Advanced Materials, ACS Nano,Small, Biomaterials等一流SCI期刊发表学术论文140余篇;撰写专著章节5部;申请专利50余项。
王湘麟讲席教授:南方科技大学材料科学与工程系终身教授,深圳市重点实验室副主任,广东省重点实验室学习委员会主任,材料基因大装置制备平台主任;主要研究有机聚合物材料的制备和有机无机复合材料在锂离子电池、钙钛矿太阳能电池、生物成像和生物传感器上的应用。以作者及共同作者在Science, Nature Nanotechnology, PNAS, Journal of the American Chemical Society, Chemical Society Review, and Advanced Materials等国际权威学术期刊上发表论文190多篇,被引次数超过14700次,H-Index为58。
陈柔羲副教授:南方科技大学材料科学与工程系与创新创业学院副教授/副研究员,硕士生导师,主要从事功能性纳米纤维的制备机理与应用研究,近年来致力于基于材料基因思想,发展功能性纳米纤维的高通量制备平台,并开展在核电军工、环境过滤、特种防护、医用敷料和能源电池方面的应用,相关研究成果已发表学术论文40余篇,申请专利50余项。